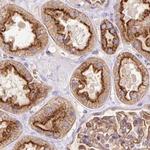
HIP1R Antibody in Immunohistochemistry (IHC)

Search
Invitrogen
HIP1R Polyclonal Antibody
{{$productOrderCtrl.translations['antibody.pdp.commerceCard.promotion.promotions']}}
{{$productOrderCtrl.translations['antibody.pdp.commerceCard.promotion.viewpromo']}}
{{$productOrderCtrl.translations['antibody.pdp.commerceCard.promotion.promocode']}}: {{promo.promoCode}} {{promo.promoTitle}} {{promo.promoDescription}}. {{$productOrderCtrl.translations['antibody.pdp.commerceCard.promotion.learnmore']}}
产品信息
PA5-58261
种属反应
宿主/亚型
分类
类型
抗原
偶联物
形式
浓度
规格
纯化类型
保存液
内含物
保存条件
运输条件
RRID
产品详细信息
Immunogen sequence: RESQEQGLRQ RLLDEQFAVL RGAAAEAAGI LQDAVSKLDD PLHLRCTSSP DYLVSRAQEA LDAVSTLEEG HAQYLTSLAD ASALVAALTR FSHLAADTII NGGATSHLA
Highest antigen sequence identity to the following orthologs: Mouse - 85%, Rat - 87%.
靶标信息
Huntingtin disease, a neurodegenerate disease, is caused by the expansion of a polymorphic glutamine tract in huntingtin. The Huntingtin Interacting Protein 1 (HIP-1) is a reportedly proapoptotic, cargo-specific adaptor protein that may be involved in the pathogenesis of Huntingtin disease. As well as playing a role in Huntingtin disease, it is likely to be involved in the recruitment of clathrin coats to lipid membranes and it may also factor in tumorigenesis by allowing the survival of precancerous and cancerous cells. Since HIP-1 expression is significantly associated with prostate and colon cancer metastasis, HIP-1 can serve as a putative prognostic factor for prostate and colon cancers.
仅用于科研。不用于诊断过程。未经明确授权不得转售。
篇参考文献 (0)
生物信息学
蛋白别名: HIP-12; HIP1-related protein; huntingtin interacting protein 12; Huntingtin-interacting protein 1-related protein; Huntingtin-interacting protein 12; unnamed protein product
基因别名: HIP12; HIP1R; HIP3; ILWEQ; KIAA0655
UniProt ID: (Human) O75146
Entrez Gene ID: (Human) 9026